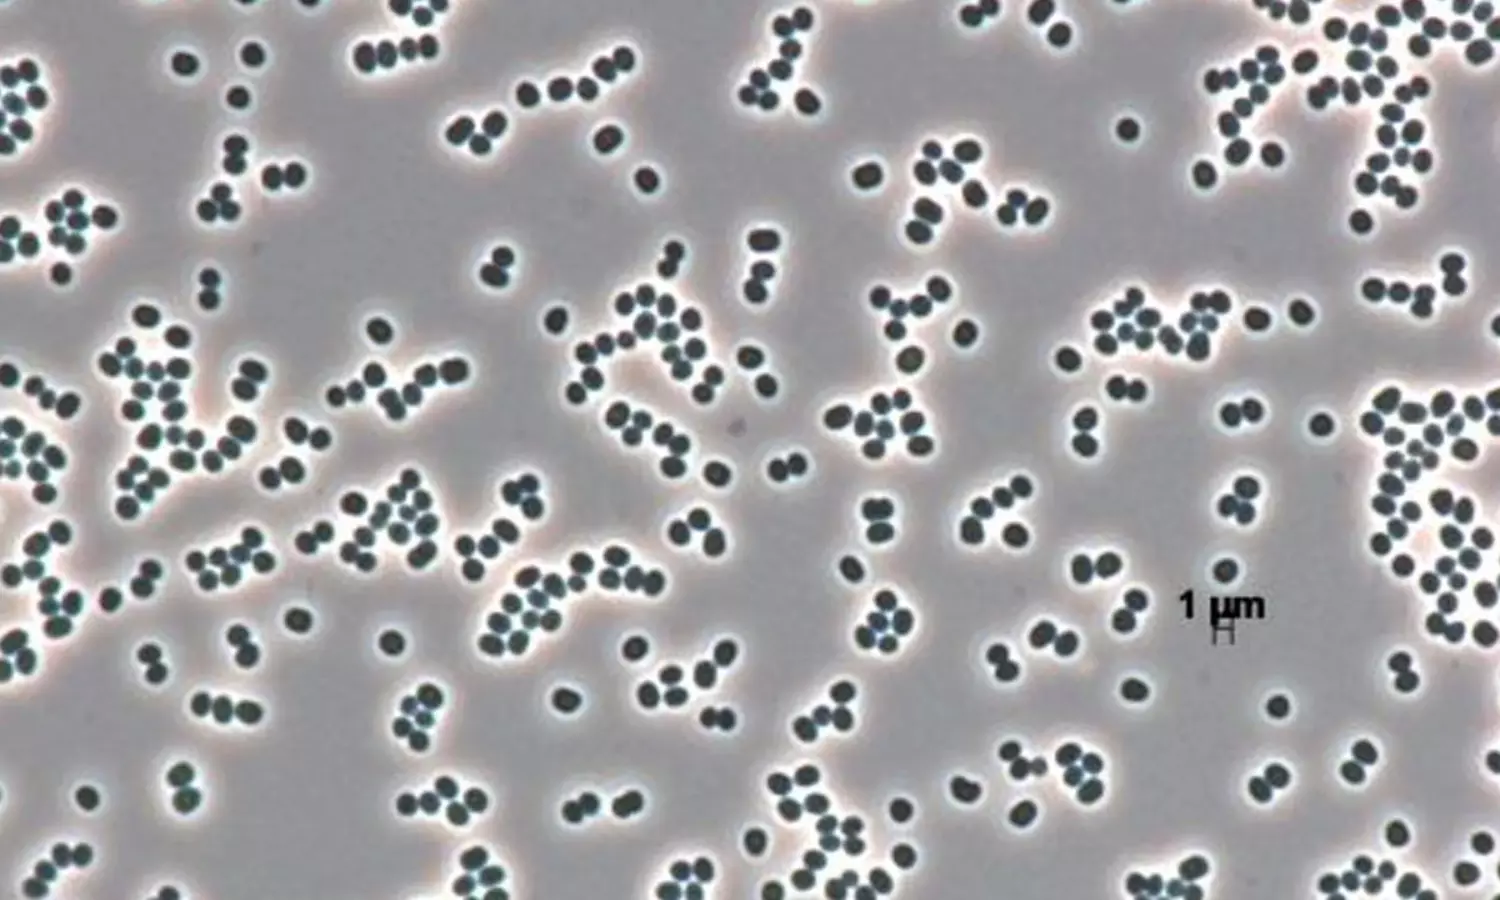
ఇదో మహానటి.. చనిపోయినట్టు నటించే బ్యాక్టీరియా..దగ్గరికెళ్ళామో..?

ఇదో మహానటి.. చనిపోయినట్టు నటించే బ్యాక్టీరియా..దగ్గరికెళ్ళామో..?
ఎప్పటికప్పుడు సైంటిస్టులు కొత్త రకం మందులను, బ్యాక్టీరియాలను కనుగొంటూనే ఉంటారు. అయితే తాజాగా అత్యంత అరుదైన ఓ బ్యాక్టీరియాను యుఎస్ సైంటిస్టులు కనుగొన్నారు.
By: Madhu Reddy | 5 Dec 2025 11:36 AM ISTఎప్పటికప్పుడు సైంటిస్టులు కొత్త రకం మందులను, బ్యాక్టీరియాలను కనుగొంటూనే ఉంటారు. అయితే తాజాగా అత్యంత అరుదైన ఓ బ్యాక్టీరియాను యుఎస్ సైంటిస్టులు కనుగొన్నారు. స్పేస్ క్రాఫ్ట్ అసెంబ్లీ రూమ్స్ లాంటి భూమిపై ఉన్న అతి పరిశుభ్రమైన వాతావరణంలోను ఈ బ్యాక్టీరియా జీవించగలదని సైంటిస్టులు తెలిపారు. అంతేకాదు ఈ బ్యాక్టీరియా ఒక మహానటి. ఎందుకంటే తన మనుగడను కొనసాగించుకోవడం కోసం చనిపోకపోయినా చనిపోయినట్లు నటిస్తుందట. ఈ బ్యాక్టీరియా అంతరిక్ష నౌక అసెంబ్లీ క్లీన్ గదులలో కూడా ఉంటుందని సైంటిస్టులు తెలిపారు. ఈ బ్యాక్టీరియా పేరు టెర్సికోకస్ ఫీనిసిస్..
ప్రామాణిక సాగు పరీక్షలను ఉపయోగించి గుర్తించడం అసాధ్యం అయినప్పటికీ.. సజీవంగా ఉండడానికి అనుమతించే నిద్రాణ స్థితిలోకి ప్రవేశించిన తర్వాత కూడా ఈ జీవి మనుగడ కొనసాగగలదని సైంటిస్టుల కొత్త పరిశోధనలో బయటపడింది. సూక్ష్మజీవులు మనుగడ, ప్రస్తుత స్టెరిలైజేషన్ ప్రోటోకాల్ ల విశ్వసనీయత గురించి చాలా రోజుల నుండి ఉన్న అంచనాలకు ఇది సవాల్ విసురుతోంది.
కాబట్టి ఈ బ్యాక్టీరియా ప్రస్తుతం అందరి దృష్టిని ఆకర్షించింది.
టెర్సికోకస్ ఫీనిసిస్ ఆక్టినో బ్యాక్టీరియా సమూహానికి చెందింది. ఇది రెండు సుదూర ప్రదేశాలలో శుభ్రమైన గదుల నుండి స్వతంత్రంగా వేరు చేయబడింది. ఒకటి నాసా యొక్క కెన్నెడీ స్పేస్ సెంటర్లో, మరొకటి యూరోపియన్ ప్రయోగ కేంద్రంలో.. క్లీన్ రూమ్స్ స్థితి స్థాపకతను పరిశోధించే పరిశోధకులు ASM జర్నల్స్ ప్రచురించిన అధ్యయనం ప్రకారం చూసుకుంటే.. బ్యాక్టీరియా ఆచరణీయమైన స్థితిలోకి ప్రవేశించడం ద్వారా పర్యావరణ ఒత్తిడిని తట్టుకుంటుంది. దీని అర్థం కణాలు సజీవంగా ఉంటాయి. కానీ సాంప్రదాయ సంస్కృతి మాధ్యమంలో ఉంచినప్పుడు పెరగవు.
అంతరిక్ష నౌక అసెంబ్లీ ప్రాంతాలలో పోషకాల కొరత, దీర్ఘకాలిక ఎండబెట్టడం అనే రెండు సాధారణ పరిస్థితులు బ్యాక్టీరియా నిద్రాణ స్థితికి మారడానికి కారణం అవుతాయని అధ్యయనం తెలుపుతోంది. ప్రయోగం చేసే సమయంలో కాలనీ ఏర్పడే యూనిట్లలో గమనించిన తగ్గుదల మొదట్లో టెర్సికోకస్ స్టెరిలైజేషన్ విధానాల ద్వారా తొలగించబడిందని సూచించింది.
అయితే మైక్రోస్కోప్ విశ్లేషణ మొత్తం కనగణనలు స్థిరంగా ఉన్నాయని వెల్లడించింది. ఇది కణాలు విభజించడాన్ని ఆపివేసిందని సూచిస్తుంది. అయితే సంబంధిత ఆక్టినో బ్యాక్టీరియాను మేల్కొల్పే ప్రోటీన్ అయిన పునర్జీవ ప్రోత్సాహక కారకాన్ని జోడించడం ద్వారా పరిశోధకులు ఈ నిద్రాణ కణాలను పునరుద్ధరించారు. ఈ కారకానికి గురైన తర్వాత గతంలో గుర్తించలేని కణాలు తిరిగి పెరుగుదలను ప్రారంభించాయి. దాంతో ఇది బ్యాక్టీరియా చనిపోలేదని మరియు సంస్కృతి ఆధారిత పద్ధతులు మాత్రమే వాటి ఉనికిని తక్కువగా అంచనా వేస్తాయని నిర్ధారించింది.
ఈ పరిశోధనలు తక్షణ వృద్ధి సామర్థ్యం ఉన్న జీవులను మాత్రమే నమోదు చేసే గుర్తింపు విధానాల్లో ఉన్న ఆంతర్యాన్ని హైలైట్ చేశాయి. ఇది ఇతర పర్యావరణ సూక్ష్మజీవులు సాధారణ స్టెరిలైజేషన్ తనిఖీల సమయంలో గుర్తింపు నుండి తప్పించుకునే అవకాశాన్ని సృష్టిస్తుంది.అయితే అంతరిక్ష సంస్థలు కఠినమైన గ్రహ రక్షణ విధానాలను నిర్వహిస్తాయి. ఎందుకంటే అంతరిక్ష నౌకలో ప్రయాణించే ఏదైనా సూక్ష్మజీవి ఇతర గ్రహాలపై జీవాన్ని గుర్తించే లక్ష్యంతో చేసే మిషన్లను నాశనం చేస్తుంది.
అందువల్ల శుభ్రమైన గదులు చాలా తక్కువ స్థాయిలో జీవసంబంధమైన పదార్థాలు కలిగి ఉండేలా రూపొందించబడ్డాయి. కానీ ఇలాంటి పరిస్థితులలో టెర్సికోకస్ ఫీనిసిస్ బతికి ఉండగల సామర్థ్యం ఉంటుందని తెలియడంతో శాస్త్రవేత్తలకు ఇది ఒక సవాల్ గా మారింది.ఈ జీవులు అసెంబ్లీ విధానాలను తట్టుకొని అంతర్ గ్రహప్రయాణ సమయంలో ఆచరణీయంగా ఉంటే మరొక ఖగోళ శరీరంపై మరింత అనుకూలమైన పరిస్థితులకు గురైన తర్వాత కూడా అవి పునరుద్ధరించబడతాయి.ఇది జీవ గుర్తింపు ప్రయోగాలలో తప్పుడు సంకేతాల అవకాశాన్ని సృష్టించడం ద్వారా శాస్త్రీయ సమగ్రతకు ముప్పు కలిగిస్తుందట. అంతేకాదు ఇది అంతరిక్షం దాటి విస్తరిస్తుందని తెలుస్తుంది. టెర్సికోకస్ ఫీనిసిస్ యొక్క స్థితిస్థాపకత అంతరిక్ష నౌక అసెంబ్లీ సౌకర్యాలకు మరింత అధునాతన సూక్ష్మజీవుల పర్యవేక్షణ వ్యవస్థలు అవసరమని సూచిస్తుంది. మాలిక్యులర్ సీక్వెన్సింగ్, మెటబాలిక్ మార్కర్లు మరియు పునర్జీవన ఆధారిత పరీక్షలను కలిపే ప్రోటోకాల్ ల సాంప్రదాయ పరీక్షలు కనిపించని కణాలను గుర్తించగలవు. గ్రహ కార్యకలాపాలు మరింత ప్రతిష్టాత్మకంగా మారుతూ మార్స్ యూరోపా లేదా ఎన్సెలాడస్ వంటి ప్రదేశాలను లక్ష్యంగా చేసుకుంటుంది కాబట్టి కాలుష్యాన్ని నివారించడం అవసరం అని శాస్త్రవేత్తలు తేల్చేశారు.